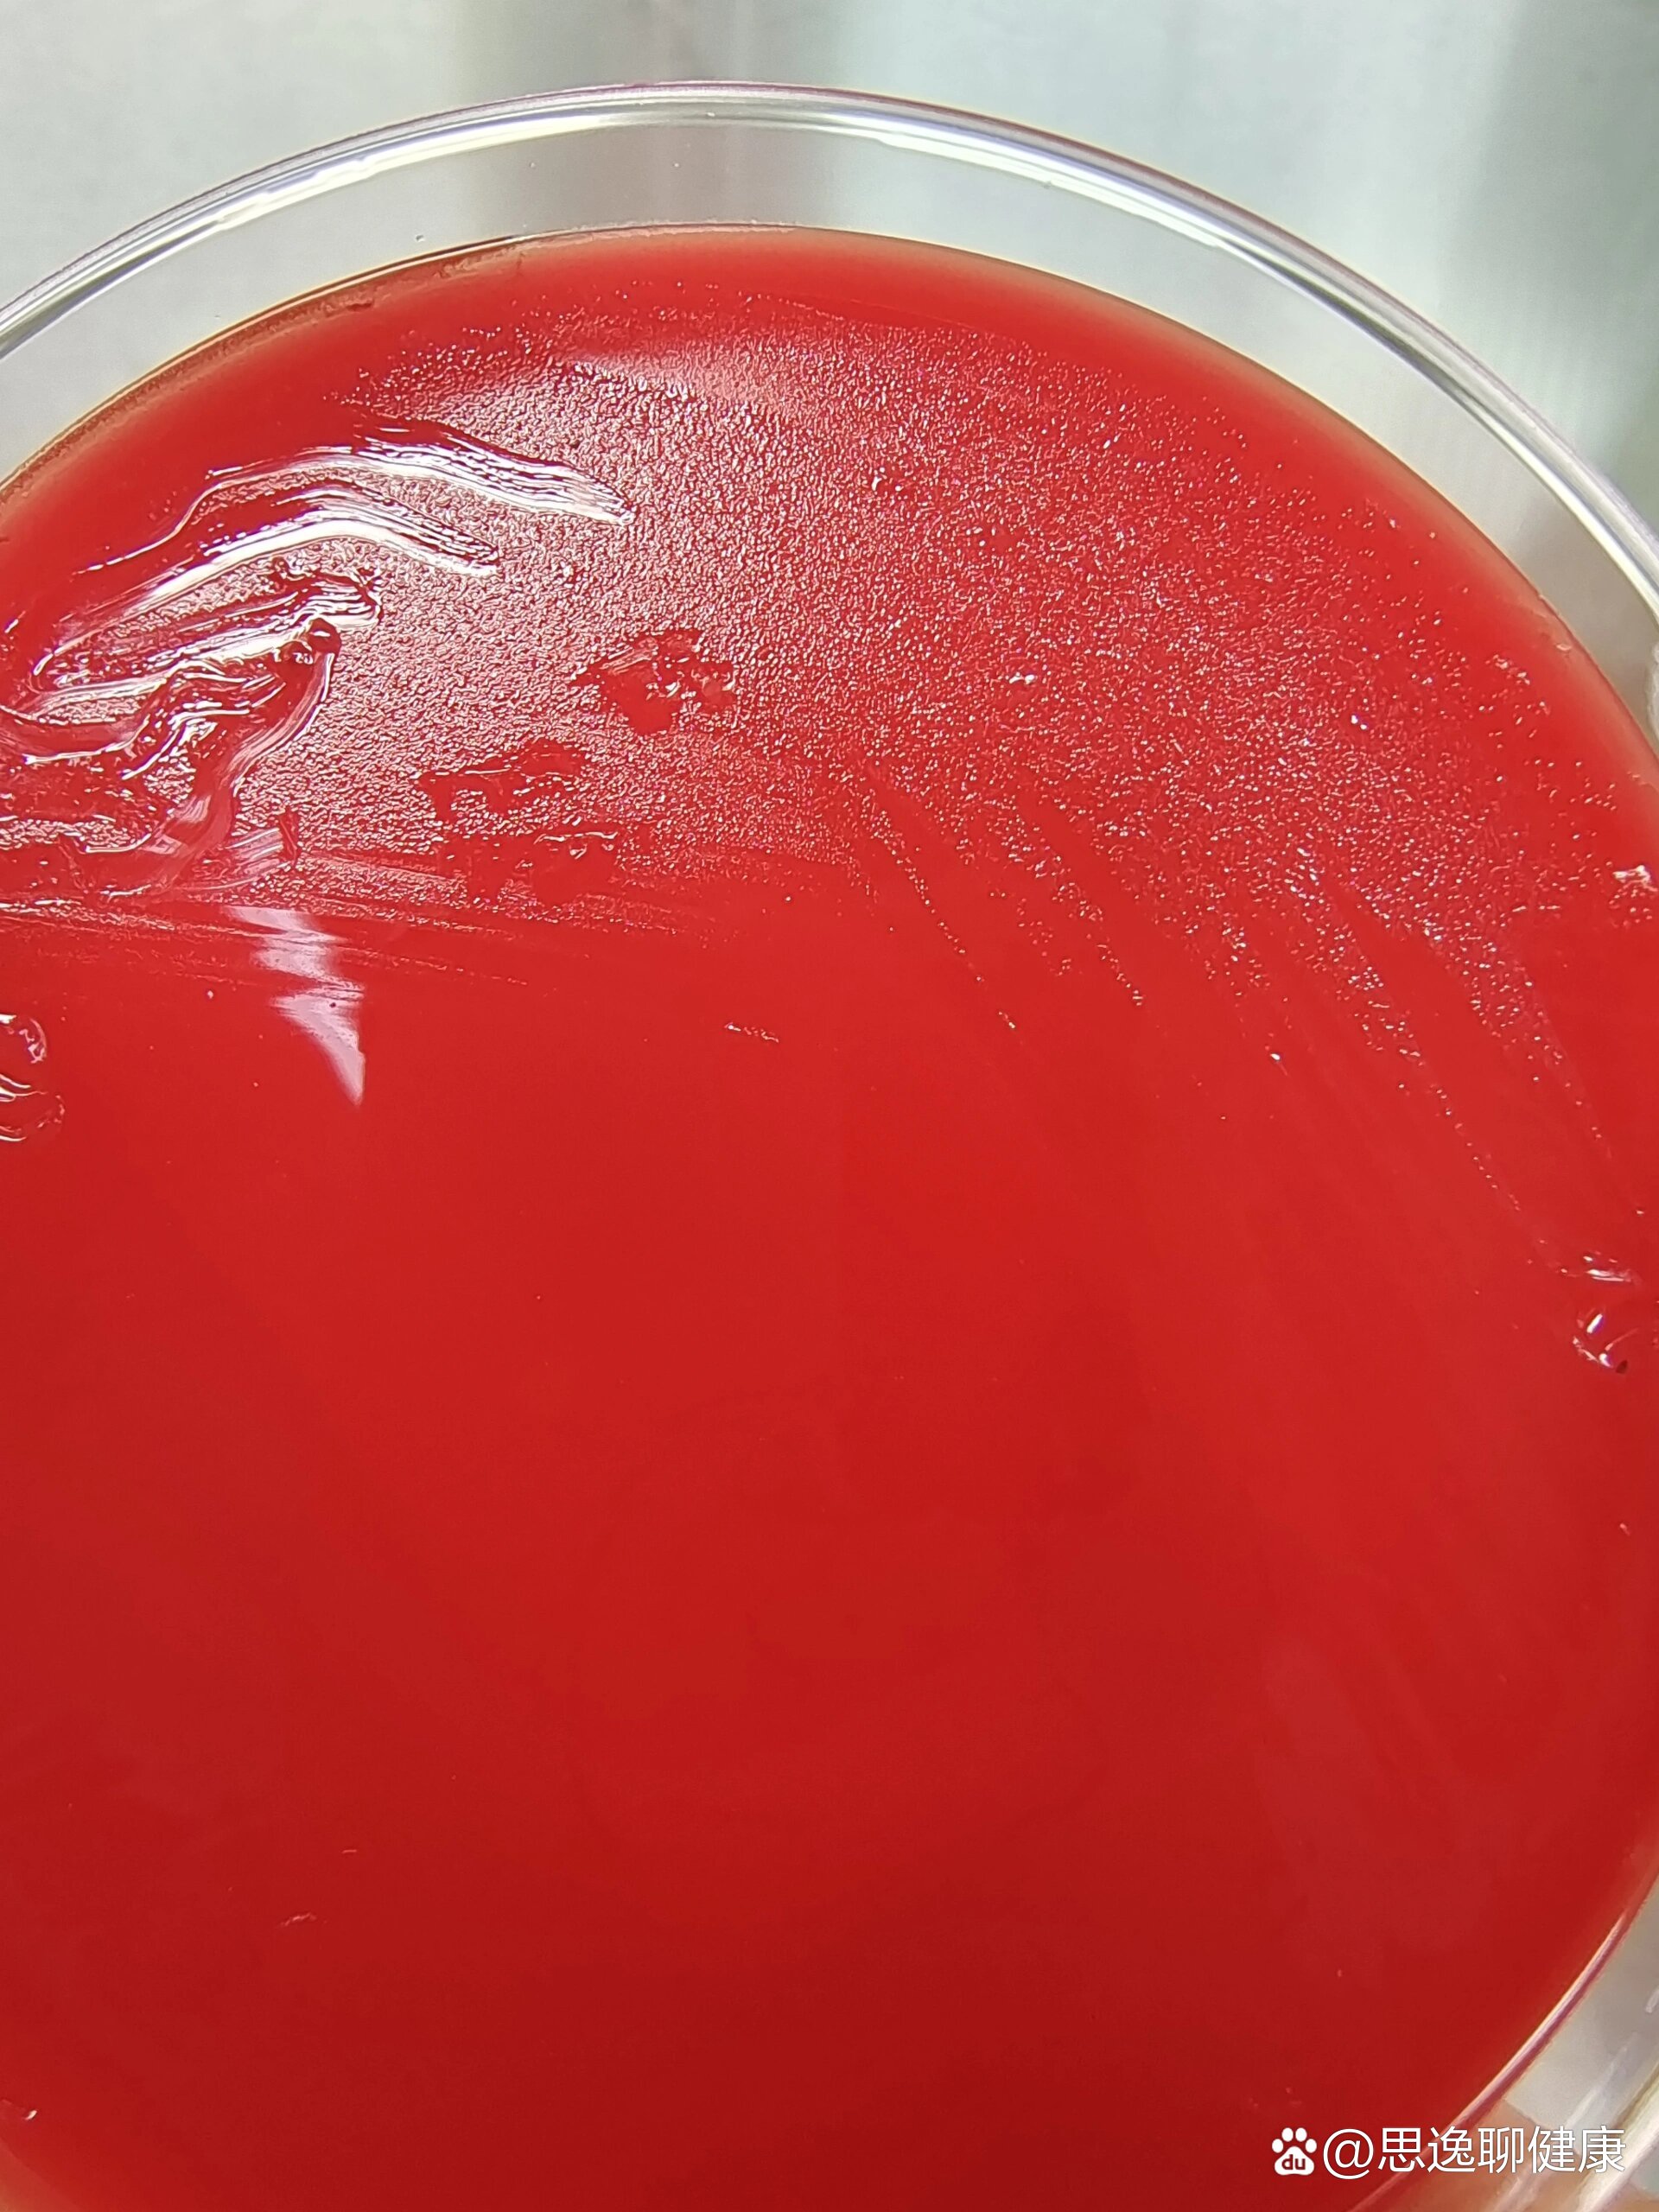
血培养,布鲁氏菌

儿童血培养

今天为病员抽血培养所以复习哈!
图片尺寸1280x1280
检验标本采集预防血培养污染这样做是关键
图片尺寸958x745
血培养:抽先需氧瓶还是厌氧瓶
图片尺寸1242x1660
91采血针采血顺序: 08血培养瓶(先需氧后 - 抖音
图片尺寸706x942
亲子鉴定纱布血(血痕,血斑)的采集方法
图片尺寸902x511
科普:血培养检查的作用是什么
图片尺寸1242x1660
新生儿桡动脉穿刺在护理临床工作中的应用|血管|针头_新浪新闻
图片尺寸700x526
血培养,布鲁氏菌
图片尺寸1920x2560
儿童血培养规范化标本采集
图片尺寸1280x640
血培养问与答ppt
图片尺寸1080x810
青春检验站一文看懂血培养
图片尺寸678x422
「转发」儿童血培养规范化标本采集的中国专家共识
图片尺寸510x1469
充电day4:血培养到底先采哪瓶?
图片尺寸1280x960
榆林市儿童医院榆阳区人民医院儿童血培养检测免费啦!
图片尺寸1942x1139
宝宝抽血后吃什么补血 儿童抽血之后吃什么补血
图片尺寸640x480
血培养的简介
图片尺寸4000x3000
多个指南不统一,儿童血培养到底该抽几毫升?
图片尺寸639x580
近一年,几乎每个月都会扁桃体发炎一次,有时候一个月
图片尺寸1080x1920
血培养:救命的检测,揭秘血液里的"小秘密"
图片尺寸913x913
"血培养"到底在培养啥?
图片尺寸1144x710